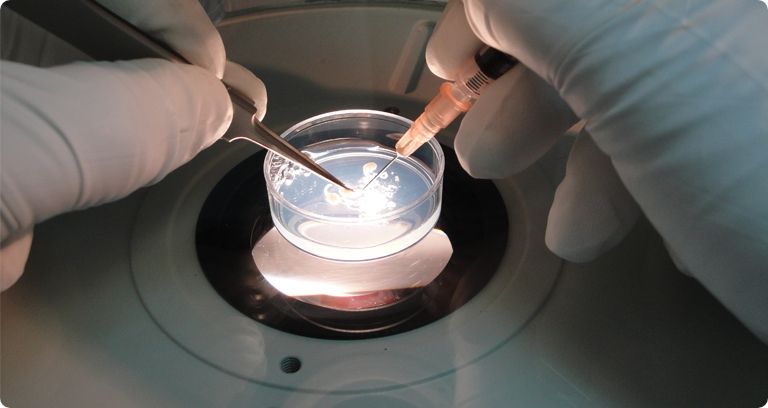
60% من الرجال في البلدان المتقدمة يعانون من انخفاض عدد الحيوانات المنوية

كارثة تهدد خصوبة الرجال في هذه الدول.. الرفاهية أم الجنس؟
إذا كان على الرجال أن يختاروا بين التمتع بخصوبتهم الجنسية أو التمتع بمظاهر الرفاهية والثراء، فماذا سيكون قرارهم؟!
أظهرت إحصائيات علمية، خلال نصف القرن الماضي، أن ما يقارب من 60% من الرجال في البلدان المتقدمة يعانون من انخفاض عدد الحيوانات المنوية في السائل المنوي.
وحاول عدد من العلماء إجراء تجارب ومسح شامل على العديد من الرجال حسب المناطق التي يعيشون فيها والعرق والنظام الغذائي الذي يتبعونه لمعرفة العلاقة بينهم وبين الخصوبة أو العقم عند الرجال.
وحسب إحصائيات علمية أوردتها وكالة سبوتنيك الروسية، تضاعف الآن في روسيا معدل عقم الذكور تقريبًا على مدار 18 عامًا، وبالتالي معدل الخصوبة عند الرجال يتجه تنازليا.
ونقلت الوكالة عن البروفيسور الروسي دميتري يينيكييف، من معهد المسالك البولية والصحة الإنجابية البشرية بجامعة سيتشينوف الروسية، قوله إن "عدد الذين انخفض معدل الخصوبة لديهم تضاعف تبعا للمنطقة التي يقطنون بها، فمثلا، في منطقة القوقاز الفيدرالية نجد 281.4 حالة لكل 100 ألف رجل، وفي المقاطعة الفيدرالية الجنوبية نجد 33.4 حالة لكل 100 ألف رجل، وهذا يعني أن هناك علاقة وطيدة بين المنطقة ومعدل الخصوبة".

وفي العقود القليلة الماضية، سجل العلماء الفرنسيون والسويسريون والأمريكيون انخفاضًا في جودة الحيوانات المنوية لدى المواطنين.
وفي عام 2017، اقترح فريق دولي من الباحثين أن هذا الوضع نموذجي بشكل عام لجميع الدول الأوروبية وأستراليا ونيوزيلندا والولايات المتحدة. بعد تحليل 185 عملاً حول هذا الموضوع، اكتشف العلماء، على مدار الأربعين عامًا الماضية، انخفاض عدد الحيوانات المنوية في السائل المنوي لسكان هذه الولايات في المتوسط بنسبة 60%، والتركيز بنسبة 52%. في الوقت نفسه، لم تعاني خصوبة الرجال في أمريكا الجنوبية وآسيا وأفريقيا كثيرًا خلال نفس الفترة، وانخفضت المعدلات بنسبة 21% و14% على التوالي.
بحسب وكالة سبوتنيك الروسية، يقول الخبراء إنه ولسوء الحظ قد تتفاقم المشكلة في المستقبل، حيث تشير الاتجاهات العالمية إلى زيادة عدد الرجال المصابين بالعقم في البلدان المتقدمة. وهناك العديد من العوامل التي تؤثر سلبًا على الخصوبة لدى الرجال، وأحد أكثرها وضوحًا هو التدخين.
ووفقا لدراسات علمية، فقد أظهرت نتائج دراسات قامت بها مجموعة من العلماء من الولايات المتحدة الأمريكية وإسرائيل، أن "عدد خلايا الحيوانات المنوية وحركتها، بالإضافة إلى المؤشرات المورفولوجية أسوأ بكثير لدى المدخنين".
وبحسب الطبيب دميتري يينيكييف، فإن "هناك تأثير سلبي مماثل أيضًا مع زيادة استهلاك الكحول، فإذا كنت تشرب أكثر من 50 مل من الكحول الإيثيلي لكل أسبوع، يمكن أن تنخفض جودة الحيوانات المنوية بشكل كبير".
ويضيف الطبيب يينيكييف: "وكذلك من بين الأسباب التي تؤثر على عقم الذكور، هناك علاقة بين ضعف البيئة وانخفاض معدل الخصوبة، حيث أن استخدام المبيدات الحشرية والمواد الكيميائية التي تدمر نظام الغدد الصماء، يمكن أن يؤثر نمط الحياة غير المستقر سلبًا على خصوبة الرجال. فعلى سبيل المثال، يعتبر النشاط البدني غير كاف، إلى جانب التلوث البيئي، فهو من الأسباب الرئيسية لانخفاض الخصوبة في أوروبا وأمريكا الشمالية".
كما يرى الخبراء أن وباء كورونا، من الممكن أنه سيؤثر على جودة الحيوانات المنوية لدى الرجال المعاصرين.
وفي نهاية العام الماضي، ظهرت العديد من الدراسات العلمية، مما يدل على أن المسار الحاد لانتشار وباء كورونا، يمكن أن يؤدي إلى العقم عند الرجال.
aXA6IDIxNi43My4yMTYuMTg4IA== جزيرة ام اند امز